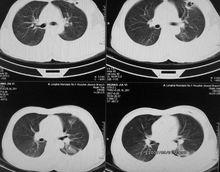
中縱隔影像圖

中縱隔
心包分類
中縱隔影像圖
中縱隔影像圖1.心包包裹心及出入心的大血管根部。分為外層的纖維心包和內層的漿膜心包。纖維心包為一底大口小的錐形囊,囊口在心的右之方與出。入心的血管外膜相移行,囊底對向膈中心腱並與之愈著。纖維心包堅韌而缺乏伸展性,當 心包腔積液時,腔內壓力升高,可壓迫心臟。漿膜心包分為髒、壁二層,壁層與纖維。心包緊密愈著,在出入心大血管根部稍上方反折為髒層,即心外膜。慢性炎症 時,髒、壁層可粘連愈著,限制。心臟舒縮。心包腔為漿膜心包髒、壁層圍成的狹窄而密閉的腔隙。腔內有少量漿液。
 心臟解剖【圖】
心臟解剖【圖】位於升主動脈、肺動脈與上腔靜脈、左心房之間的部分,稱心包橫竇, 其大小可容一指,是心血管手術阻斷血流的部位。位於兩側肺上、下靜脈,下腔靜脈、左心房後壁與心包後壁之間的部分,稱心包斜竇,心包腔積液常積聚於此而不易引流。漿膜心包壁層前部與下部移 行處所夾的腔,深1~2cm,是心包腔之一部,稱心包前下竇,位置較低,心包積液常先積聚於此。心包前壁隔著胸膜和肺與胸骨和第2~6肋軟骨為鄰,但在第4~6肋軟骨高度因胸 膜前界形成心包三角,使心包直接與左第4~6肋軟骨前部、第4~5肋間隙及胸骨下左半部相鄰,為心包裸區,可經此部位進行。已包穿刺。心包前壁有結締組織連於胸骨,稱胸骨心 包韌帶,起固定心包作用。心包後面有主支氣管、食管、胸導管、胸主動脈、奇靜脈和半奇靜脈等,兩側鄰接縱隔胸膜,並有膈神經和心包膈血管自上而下行於心包與縱隔胸膜之間。心包下面鄰下腔靜脈和膈,與膈中心腱緊密癒合,周圍部尚 易分離。上方有升主動脈、肺動脈乾和上腔靜脈。心包由心包膈動脈、肌膈動脈和食管動脈等供血,靜脈與動脈伴行,分別匯入胸廓內靜脈、奇靜脈或半奇靜脈等。心包的淋巴注入縱隔前、後淋巴結和膈上淋巴結。心包的神經來源較多。來自信叢、肺叢和食管叢,也來自膈神經、肋間神經和左喉返神經,傳遞感覺衝動,心包手術需進行麻醉。
位置
2.心包內大血管心包內近心底處有出入心的大血管。升主動脈居中,其左前方為肺動脈,右側有上腔靜脈,有後下方有下腔靜脈。右肺上、下靜脈在上腔靜脈和右心房的後方,左肺上、下靜脈在胸主動脈的前方向內行,匯入左心房。升主動脈前壁有一條由心包髒層形成的比較恆定的皺襞,稱升主動脈襞。該皺襞位於升主動脈出心室平面至心包反折線之間,內含脂肪、小血管和神經叢。由於皺襞的形態和 位置恆定,可作為心血管手術的標誌。3.心形似倒置的圓錐體,前後略扁,底朝向有後上方,尖向左前下方。心的胸助而對向胸前壁,主要由右心室和右心房構成,左心房和左心室僅占小部。膈面對向膈,大 部由左心室,小部由右心室構成。左側面對向左肺,主要由左心室構成。心右緣垂直向下,由右心房構成。左緣鈍圓,界於胸肋面與外側面之間,斜向左下,大部由左心室,小部由左心耳構成。下緣近水平位,由右心室和心尖構成。心的長軸與正中矢狀面約成45度角,並由於在發育中輕度鏇轉,使有半心大部在右前方,左半心在左後方。
認知
位置和毗鄰
(l)位置和毗鄰:心位於縱隔內,被心包所包裹,前方對胸骨體下部和第2~6肋軟骨,後方平第5~8胸椎,約2/3在前正中線左側,1/3在右側。其毗鄰關係大致與心包相似,但其上界低於心包上界,出入心的大血管和肺根結構位於心的上方,並與之相毗鄰。
體表投影心界
(2)體表投影心界:心在胸前壁的投影可用四點的連線來表示。左上點在左第2肋軟骨下緣,距胸骨側緣約1,2cm。右上點在有第3肋軟骨上緣距胸骨側緣1cm。左下點在左第5肋間隙距 前正中線7~9cm或鎖骨中線內側l~2cm。右下點在有第6胸助關節處。左、右上點的連線為心上界,左、右下點的連線為。已下界,右上、下點間作一微向有凸的弧形線為心右界,左上、下點間作一微向左凸的弧形線為心左界。心尖的投影即左下點。房室瓣和動脈瓣:在房室瓣在左第4胸肋關節平面,脊柱左側。右居室瓣在前正中線與第4肋間隙交點處,左房室瓣的右下方,脊柱的正前方。主動脈瓣在胸骨左緣第3肋間隙,對向脊柱左緣。肺動脈瓣在左第3胸肋關節處,脊柱的稍左側。

